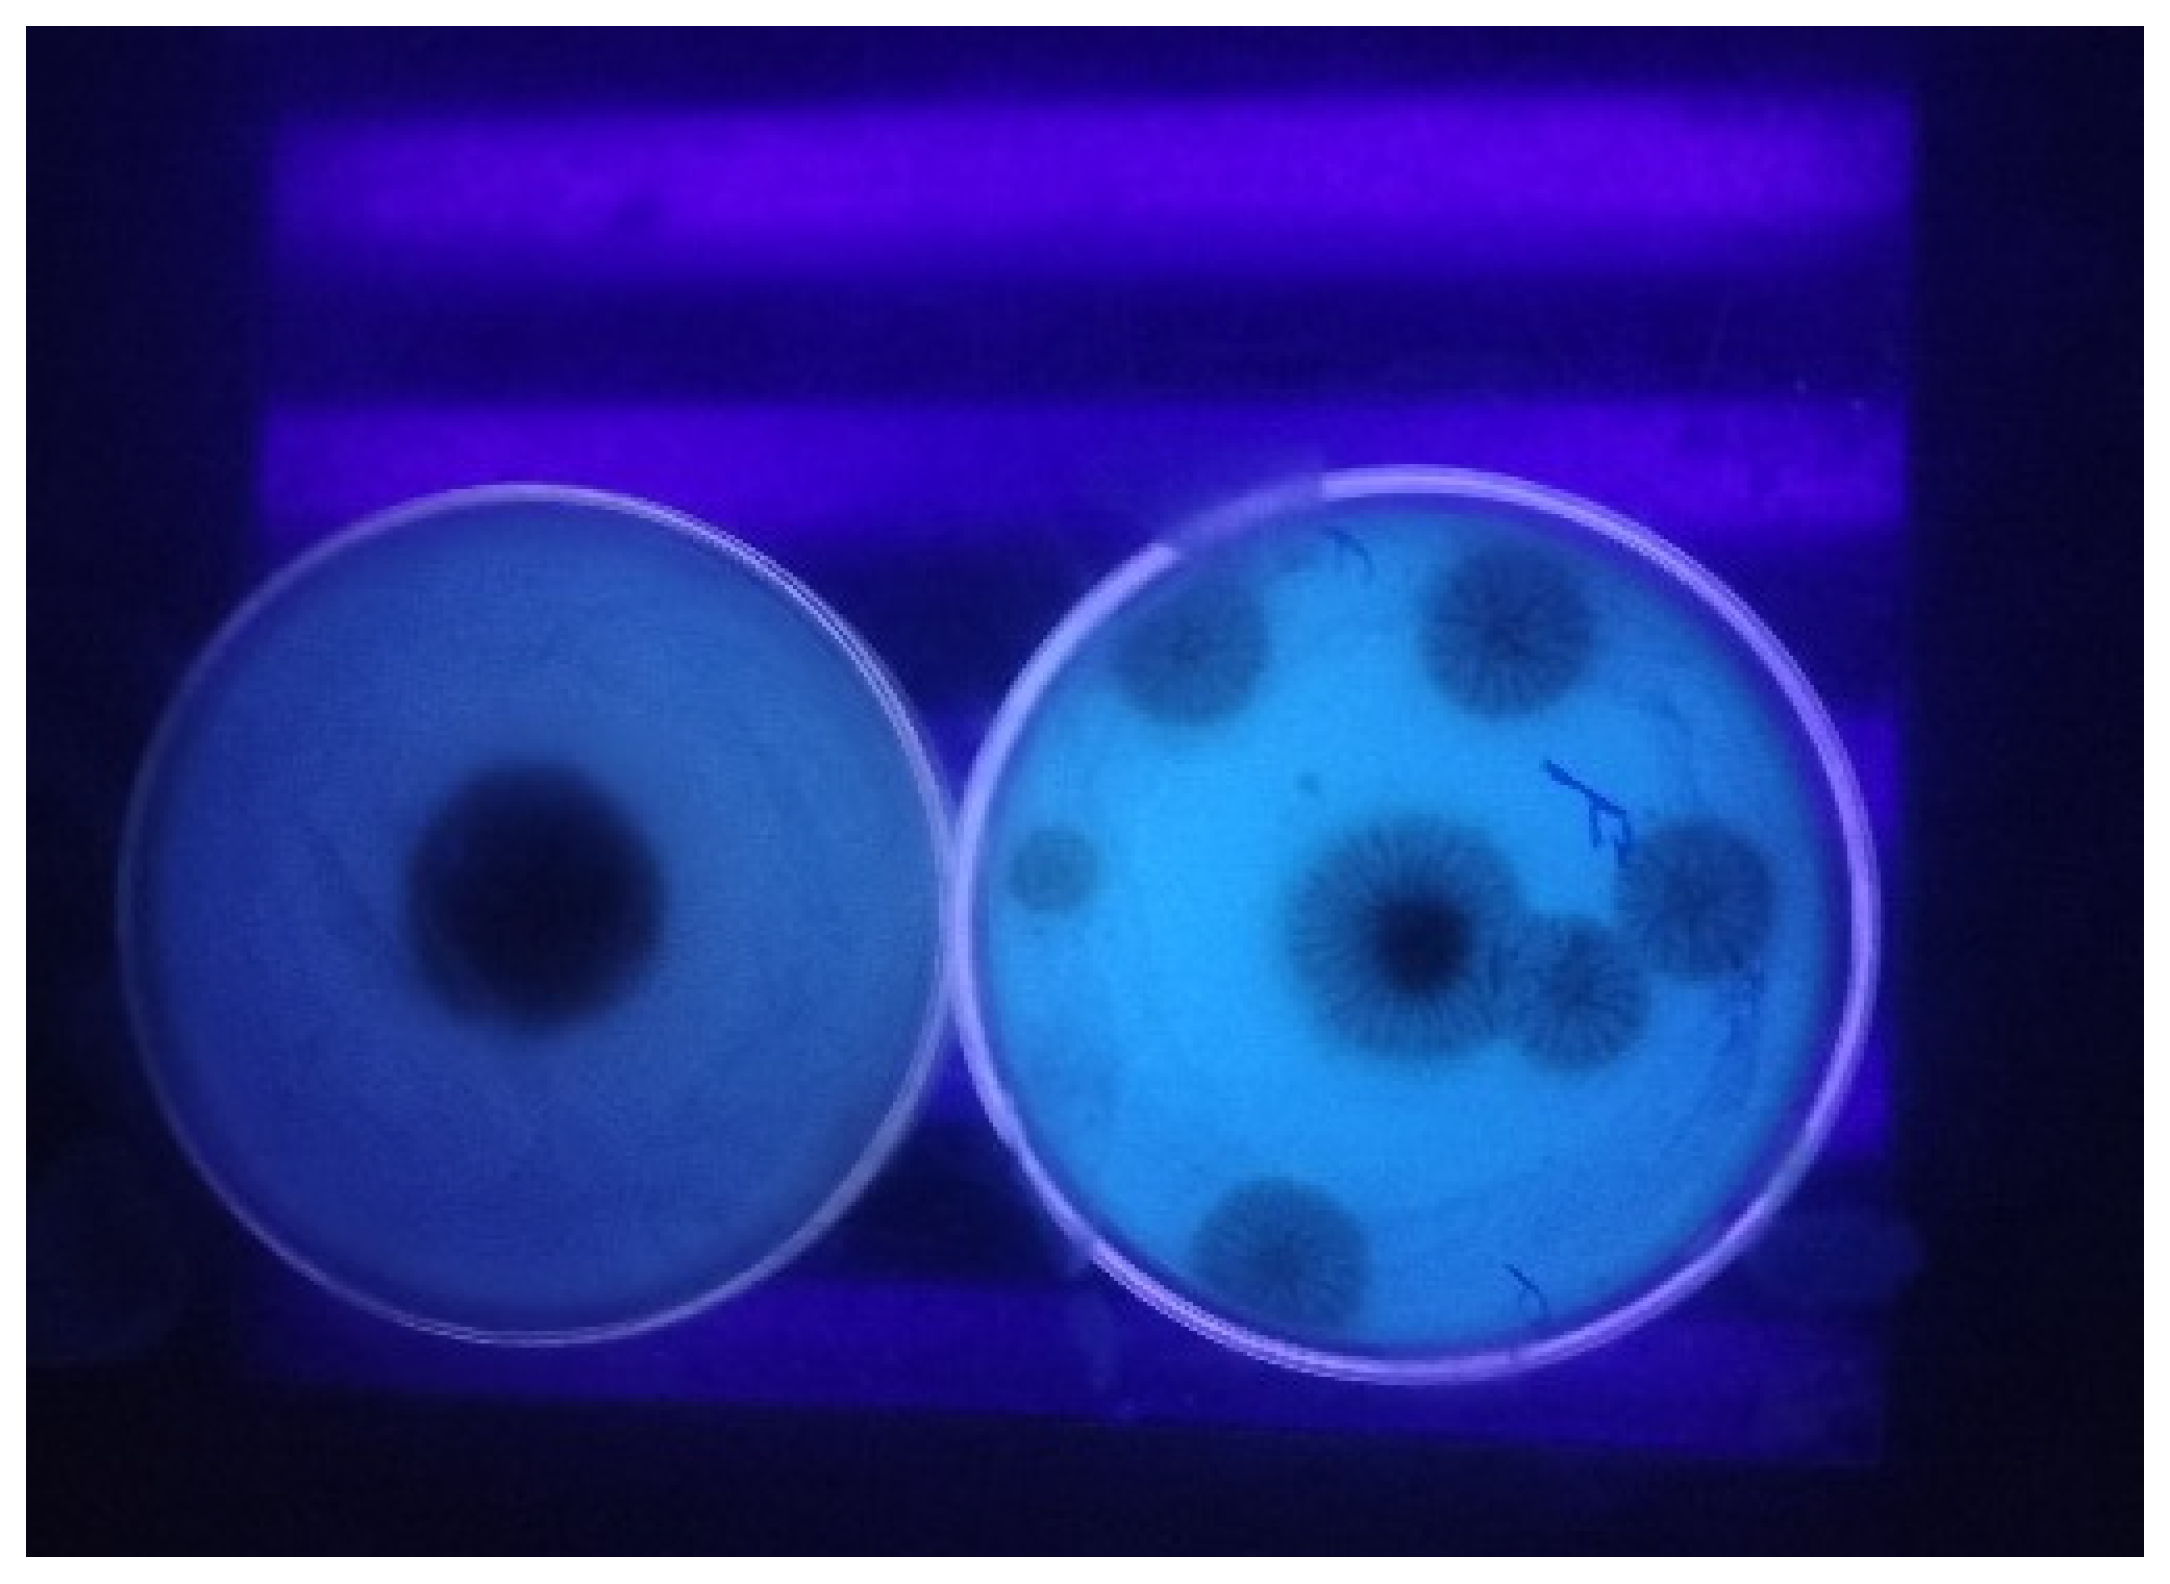
Toxins 17 00474 g002 Toxins 17 00474 g002

Ochratoxin A and Aspergillus spp. Contamination in Brown and Polished (White) Rice from Indian Markets
Abstract
1. Introduction
2. Results and Discussion
2.1. Morphological and Molecular Characterization of A. niger and A. ochraceus
2.2. Determination of Ochratoxin-Producing Potential of A. niger and A. ochraceus
2.2.1. Cultural Screening for OTA Production
2.2.2. Quantification of OTA by RP HPLC-FLD Analysis
2.3. Multipoint Calibration Curve, Linearity, and Sensitivity of the OTA Detection Method
2.4. Occurrence of OTA Contamination in Rice
3. Conclusions
4. Materials and Methods
4.1. Sample Collection
4.2. Isolation and Characterization of Ochratoxigenic Fungi
4.3. Screening of Ochratoxigenic Fungi for OTA Production
4.4. Extraction of OTA from Rice
4.5. HPLC Analysis
4.6. Method Validation and Recovery Analysis
4.7. Statistical Analysis
Author Contributions
Funding
Institutional Review Board Statement
Informed Consent Statement
Data Availability Statement
Acknowledgments
Conflicts of Interest
References
- Troestch, J.; Reyes, S.; Vega, A. Determination of Mycotoxin Contamination Levels in Rice and Dietary Exposure Assessment. J. Toxicol. 2022, 3596768. [Google Scholar] [CrossRef] [PubMed]
- Verma, D.K.; Shukla, K. Nutritional Value of Rice and their Importance. J. Indian Farmers Dig. 2011, 44, 21–35. [Google Scholar]
- Statista. 2025. Available online: https://www.statista.com/ (accessed on 14 April 2025).
- Reddy, K.R.N.; Reddy, C.S.; Muralidharan, K. Detection of Aspergillus spp. and Aflatoxin B1 in Rice in India. Food Microbiol. 2009, 26, 27–31. [Google Scholar] [CrossRef] [PubMed]
- Sun, Q.; Spiegelman, D.; Van Dam, R.M.; Holmes, M.D.; Malik, V.S.; Willett, W.C.; Hu, F.B. White rice, Brown rice, and Risk of Type 2 Diabetes in US men and Women. Arch. Intern. Med. 2010, 170, 961–969. [Google Scholar] [CrossRef]
- Reddy, K.R.N.; Reddy, C.S.; Abbas, H.K.; Abel, C.A.; Muralidharan, K. Mycotoxigenic fungi, mycotoxins and management of rice grains. Toxin Rev. 2008, 27, 287–317. [Google Scholar] [CrossRef]
- Higazy, N.S.; Saleh, A.E.; Hassan, Z.U.; Al Thani, R.; Migheli, Q.; Jaoua, S. Investigation and Application of Bacillus pumilus QBP344-3 in the Control of Aspergillus carbonarius and Ochratoxin A Contamination. Food Control 2021, 119, 107464. [Google Scholar] [CrossRef]
- Majumder, S.; Bala, B.K.; Arshad, F.M.; Haque, M.A.; Hossain, M.A. Food security through increasing technical efficiency and reducing postharvest losses of rice production systems in Bangladesh. Food Secur. 2016, 8, 361–374. [Google Scholar] [CrossRef]
- Hamad, G.M.; Mehany, T.; Simal-Gandara, J.; Abou-Alella, S.; Esua, O.J.; Abdel-Wahhab, M.A.; Hafez, E.E. A review of recent innovative strategies for controlling mycotoxins in foods. Food Control 2023, 144, 109350. [Google Scholar] [CrossRef]
- Cuciureanu, M.; Tuchiluș, C.; Vartolomei, A.; Tamba, B.I.; Filip, L. An Immunoenzymatic Method for the Determination of Ochratoxin A in Biological Liquids (Colostrum and Cow’s Milk). Toxins 2021, 13, 673. [Google Scholar] [CrossRef] [PubMed]
- Bryła, M.; Ksieniewicz-Woźniak, E.; Stępniewska, S.; Modrzewska, M.; Waśkiewicz, A.; Szymczyk, K.; Szafrańska, A. Transformation of ochratoxin A during bread-making processes. Food Control 2021, 125, 107950. [Google Scholar] [CrossRef]
- Agriopoulou, S.; Stamatelopoulou, E.; Varzakas, T. Advances in occurrence, importance, and mycotoxin control strategies: Prevention and detoxification in foods. Foods 2020, 9, 137. [Google Scholar] [CrossRef] [PubMed]
- Kumar, P.; Mahato, D.K.; Sharma, B.; Borah, R.; Haque, S.; Mahmud, M.M.C.; Shah, A.K.; Rawal, D.; Bora, H.; Bui, S. Ochratoxins in food and feed: Occurrence and its impact on human health and management strategies. Toxicon 2020, 187, 151–162. [Google Scholar] [CrossRef] [PubMed]
- Li, X.; Ma, W.; Ma, Z.; Zhang, Q.; Li, H. The Occurrence and Contamination Level of Ochratoxin A in Plant and Animal-Derived Food Commodities. Molecules 2021, 26, 6928. [Google Scholar] [CrossRef]
- Li, X.; Ma, W.; Ma, Z.; Zhang, Q.; Li, H. Recent progress in determination of ochratoxin a in foods by chromatographic and mass spectrometry methods. Crit. Rev. Food Sci. Nutr. 2022, 62, 5444–5461. [Google Scholar] [CrossRef] [PubMed]
- Corrêa, J.A.F.; Nazareth, T.d.M.; Meca, G.; Luciano, F.B. A small-scale ochratoxin A production method for rapid and affordable assay for screening microorganisms for their ability to degrade the mycotoxin. LWT 2022, 156, 113058. [Google Scholar] [CrossRef]
- Wang, Y.; Yan, H.; Neng, J.; Gao, J.; Yang, B.; Liu, Y. The Influence of NaCl and Glucose Content on Growth and Ochratoxin A Production by Aspergillus ochraceus, Aspergillus carbonarius and Penicillium nordicum. Toxins 2020, 12, 515. [Google Scholar] [CrossRef]
- Akbar, A.; Medina, A.; Magan, N. Impact of interacting climate change factors on growth and ochratoxin A production by Aspergillus section Circumdati and Nigri species on coffee. World Mycotoxin J. 2016, 9, 863–874. [Google Scholar] [CrossRef]
- Marc, R.A. Implications of Mycotoxins in Food Safety. In Mycotoxins and Food Safety—Recent Advances; Marc, R.A., Ed.; IntechOpen: Rijeka, Croatia, 2022. [Google Scholar] [CrossRef]
- Salasib, A. A Review of Ochratoxin A Occurrence, Condition for the Formation and Determination Methods. J. Drug Des. Med. Chem. 2020, 6, 15–21. [Google Scholar] [CrossRef]
- Mutlu-İngök, A.; Elikoğlu, C.; Temir, H.N.; Karbancıoğlu-Güler, F.J. Growth and ochratoxin A production by Aspergillus carbonarius isolated from dried figs in aegean region of Turkey affected by temperature and water activity. Sak. Univ. J. Sci. 2020, 24, 140–150. [Google Scholar] [CrossRef]
- Hadi, A.; Al Hussaini, I.; Al-Janabi, J. Occurrence, Characterizations of Ochratoxin a and Molecular Identification of Aspergillus ochraceous Contaminating Dried Fruits. Ann. Rom. Soc. Cell Biol. 2021, 25, 13811–13826. Available online: http://annalsofrscb.ro/index.php/journal/article/view/4508 (accessed on 18 August 2025).
- Pfliegler, W.P.; Pusztahelyi, T.; Pocsi, I. Mycotoxins—Prevention and decontamination by yeasts. J. Basic Microbiol. 2015, 55, 805–818. [Google Scholar] [CrossRef]
- Gil-Serna, J.; Vázquez, C.; Patiño, B. The Genomic Regions That Contain Ochratoxin A Biosynthetic Genes Widely Differ in Aspergillus Section Circumdati Species. Toxins 2020, 12, 754. [Google Scholar] [CrossRef] [PubMed]
- Santos, A.R.; Carreiró, F.; Freitas, A.; Barros, S.; Brites, C.; Ramos, F.; Sanches Silva, A. Mycotoxins contamination in rice: Analytical methods, occurrence and detoxification strategies. Toxins 2022, 14, 647. [Google Scholar] [CrossRef]
- European Commission. Commission Regulation (EU) 2023/915 of 25 April 2023 on maximum levels for certain contaminants in food and repealing Regulation (EC) No 1881/2006. Off. J. Eur. Union 2023, 119, 103–157. [Google Scholar]
- Rahi, S.; Choudhari, P.; Ghormade, V. Aflatoxin and Ochratoxin A Detection: Traditional and Current Methods. In Advancing Frontiers in Mycology & Mycotechnology: Basic and Applied Aspects of Fungi; Satyanarayana, T., Deshmukh, S.K., Deshpande, M.V., Eds.; Springer: Singapore, 2019; pp. 377–404. [Google Scholar] [CrossRef]
- Laut, S.; Poapolathep, S.; Piasai, O.; Sommai, S.; Boonyuen, N.; Giorgi, M.; Zhang, Z.; Fink-Gremmels, J.; Poapolathep, A. Storage fungi and mycotoxins associated with rice samples commercialized in Thailand. Foods 2023, 12, 487. [Google Scholar] [CrossRef]
- Klich, M.A. Biogeography of Aspergillus species in soil and litter. Mycologia 2002, 94, 21–27. [Google Scholar] [CrossRef]
- Silva, D.M.; Batista, L.R.; Rezende, E.F.; Fungaro, M.H.P.; Sartori, D.; Alves, E. Identification of fungi of the genus Aspergillus section Nigri using polyphasic taxonomy. Braz. J. Microbiol. 2011, 42, 761–773. [Google Scholar] [CrossRef]
- Awad, M.; Albogami, B.; Mwabvu, T.; Hassan, M.; Baazeem, A.; Hassan, M.; Elsharkawy, M. Identification and Biodiversity Patterns of Aspergillus species Isolated from Some Soil Invertebrates at High Altitude using Morphological Characteristics and Phylogenetic Analyses. PeerJ 2023, 11, e15035. [Google Scholar] [CrossRef]
- Visagie, C.M.; Varga, J.; Houbraken, J.; Meijer, M.; Kocsubé, S.; Yilmaz, N.; Fotedar, R.; Seifert, K.A.; Frisvad, J.C.; Samson, R.A. Ochratoxin production and taxonomy of the yellow aspergilli (Aspergillus section Circumdati). Stud. Mycol. 2014, 78, 1–61. [Google Scholar] [CrossRef] [PubMed]
- Frisvad, J.C.; Frank, J.M.; Houbraken, J.; Kuijpers, A.F.A.; Samson, R.A. New ochratoxin A producing species of Aspergillus section Circumdati. Stud. Mycol. 2004, 50, 23–43. [Google Scholar]
- Abdallah, Y.; Ul Hassan, Z.; Al-Thani, R.; Al-Shamary, N.; Al-Yafei, T.; Alnaimi, H.; Jaoua, S. Prevalence of toxigenic mycobiota and mycotoxins in date palm fruits and investigation on Bacillus cereus 342-2 as biocontrol agent. Biocontrol Sci. Technol. 2022, 32, 1372–1388. [Google Scholar] [CrossRef]
- Alsalabi, F.A.; Hassan, Z.U.; Al-Thani, R.F.; Jaoua, S. Molecular Identification and Biocontrol of Ochratoxigenic Fungi and Ochratoxin A in Animal Feed Marketed in the State of Qatar. Heliyon 2023, 9, e12835. [Google Scholar] [CrossRef]
- Nandinidevi, S.; Jayapradha, C.; Paranidharan, V. Investigating the Ochratoxin Production Potential of Aspergillus spp in Indian Rice: A Comprehensive Study. Int. J. Plant Soil Sci. 2024, 36, 206–215. [Google Scholar] [CrossRef]
- Heenan, C.N.; Shaw, K.J.; Pitt, J.I. Ochratoxin A production by Aspergillus carbonarius and A. niger isolates and detection using coconut cream agar. J. Food Mycol. 1998, 1, 67–72. [Google Scholar]
- Joosten, H.M.L.J.; Goetz, J.; Pittet, A.; Schellenberg, M.; Bucheli, P. Production of ochratoxin A by Aspergillus carbonarius on coffee cherries. Int. J. Food Microbiol. 2001, 65, 39–44. [Google Scholar] [CrossRef] [PubMed]
- Palumbo, J.D.; O’keeffe, T.L.; Ho, Y.S.; Santillan, C.J. Occurrence of ochratoxin A contamination and detection of ochratoxigenic Aspergillus species in retail samples of dried fruits and nuts. J. Food Prot. 2015, 78, 836–842. [Google Scholar] [CrossRef]
- Kuntawee, S.; Akarapisan, A. Isolation and identification of Aspergillus species producing Ochratoxin A in Arabica coffee beans. J. Agric. Technol. 2015, 11, 1235–1242. [Google Scholar]
- Chebil, S.; Rjiba-Bahri, W.; Oueslati, S.; Ben Ismail, H.; Ben-Amar, A.; Natskoulis, P. Ochratoxigenic fungi and Ochratoxin A determination in dried grapes marketed in Tunisia. Ann. Microbiol. 2020, 70, 38. [Google Scholar] [CrossRef] [PubMed]
- El Sayed, T.I.; El Desouky, T.A. Abd EAAM. Investigation of fungus associated within co-occurrence of aflatoxins and ochratoxin a in cereals from Egypt. MOJ Toxicol. 2019, 5, 92–99. [Google Scholar] [CrossRef]
- Park, J.W.; Choi, S.-Y.; Hwang, H.-J.; Kim, Y.-B. Fungal mycoflora and mycotoxins in Korean polished rice destined for humans. Int. J. Food Microbiol. 2005, 103, 305–314. [Google Scholar] [CrossRef]
- Rahmani, A.; Jinap, S.; Soleimany, F. Validation of the procedure for the simultaneous determination of aflatoxins ochratoxin A and zearalenone in cereals using HPLC-FLD. Food Addit. Contam. Part A 2010, 27, 1683–1693. [Google Scholar] [CrossRef]
- Zinedine, A.; Soriano, J.M.; Juan, C.; Mojemmi, B.; Moltó, J.C.; Bouklouze, A.; Cherrah, Y.; Idrissi, L.; Aouad, R.E.; Mañes, J. Incidence of ochratoxin A in rice and dried fruits from Rabat and Sale area, Morocco. Food Addit. Contam. 2007, 24, 285–291. [Google Scholar] [CrossRef]
- Hassan, H.F.; Abou Ghaida, A.; Charara, A.; Dimassi, H.; Faour, H.; Nahouli, R.; Karam, L.; Alwan, N. Exposure to Ochratoxin A from Rice Consumption in Lebanon and United Arab Emirates: A Comparative Study. Int. J. Environ. Res. Public Health 2022, 19, 11074. [Google Scholar] [CrossRef] [PubMed]
- Gonzalez, L.; Juan, C.; Soriano, J.M.; Molto, J.C.; Manes, J. Occurrence and daily intake of ochratoxin A of organic and non-organic rice and rice products. Int. J. Food Microbiol. 2006, 107, 223–227. [Google Scholar] [CrossRef] [PubMed]
- Zhai, C.K.; Lu, C.M.; Zhang, X.Q.; Sun, G.J.; Lorenz, K.J. Comparative study on nutritional value of Chinese and North American wild rice. J. Food Compos. Anal. 2001, 14, 371–382. [Google Scholar] [CrossRef]
- Medina, A.; Gonzalez, G.; Saez, J.M.; Mateo, R.; Jimenez, M. Bee pollen, a substrate that stimulates ochratoxin A production by Aspergillus ochraceus Wilh. Syst. Appl. Microbiol. 2004, 27, 261–267. [Google Scholar] [CrossRef]
- Chandravarnan, P.; Agyei, D.; Ali, A. The prevalence and concentration of mycotoxins in rice sourced from markets: A global description. Trends Food Sci. Technol. 2024, 146, 104394. [Google Scholar] [CrossRef]
- Aydin, A.; Aksu, H.; Gunsen, U. Mycotoxin levels and incidence of mould in Turkish rice. Environ. Monit. Assess. 2011, 178, 271–280. [Google Scholar] [CrossRef]
- Moharram, A.M.; Yasser, M.M.; Sayed, M.A.; Omar, O.A.; Idres, M.M.M. Mycobiota and mycotoxins contaminating rice grains in El-Minia, Governorate, Egypt. Biosci. Biotechnol. Res. Asia 2019, 16, 167–178. [Google Scholar] [CrossRef]
- Scudamore, K.A.; Hetmanski, M.T.; Chan, H.K.; Collins, S. Occurrence of mycotoxins in raw ingredients used for animal feeding stuffs in the United Kingdom in 1992. Food Addit. Contam. 1997, 14, 157–173. [Google Scholar] [CrossRef]
- Rahimi, E. The occurrence of ochratoxin A in rice in six provinces of Iran. Toxicol. Ind. Health 2014, 32, 1324–1327. [Google Scholar] [CrossRef]
- Lai, X.; Liu, R.; Ruan, C.; Zhang, H.; Liu, C. Occurrence of aflatoxins and ochratoxin A in rice samples from six provinces in China. Food Control 2015, 50, 401–404. [Google Scholar] [CrossRef]
- Samsudin, N.I.P.; Abdullah, N. A preliminary survey on the occurrence of mycotoxigenic fungi and mycotoxins contaminating red rice at consumer level in Selangor, Malaysia. Mycotoxin Res. 2013, 29, 89–96. [Google Scholar] [CrossRef]
- Iqbal, S.Z.; Asi, M.R.; Hanif, U.; Zuber, M.; Jinap, S. The presence of aflatoxins and ochratoxin A in rice and rice products; and evaluation of dietary intake. Food Chem. 2016, 210, 135–140. [Google Scholar] [CrossRef] [PubMed]
- Manizan, A.L.; Oplatowska-Stachowiak, M.; Piro-Metayer, I.; Campbell, K.; Koffi-Nevry, R.; Elliott, C.; Akaki, D.; Montet, D.; Brabet, C. Multi-mycotoxin determination in rice, maize and peanut products most consumed in Côte d’Ivoire by UHPLC-MS/MS. Food Control 2018, 87, 22–30. [Google Scholar] [CrossRef]
- Goncalves, A.; Gkrillas, A.; Dorne, J.L.; Dall’Asta, C.; Palumbo, R.; Lima, N.; Battilani, P.; Venancio, A.; Giorni, P. Pre- and postharvest strategies to minimize mycotoxin contamination in the rice food chain. Compr. Rev. Food Sci. Food Saf. 2019, 18, 441–454. [Google Scholar] [CrossRef] [PubMed]
- Carbon, H.N.; Lee, H.J. Varied reduction of ochratoxin A in brown and white rice during roasting. World Mycotoxin J. 2022, 15, 361–368. [Google Scholar] [CrossRef]
- Pitt, J.I.; Hocking, A.D. Methods for isolation, enumeration and identification. In Fungi and Food Spoilage; Pitt, J.I., Hocking, A.D., Eds.; Springer: Boston, MA, USA, 1997; pp. 21–57. [Google Scholar]
- Lasram, S.; Oueslati, S.; Jouira, H.B.; Chebil, S.; Mliki, A.; Ghorbel, A. Identification of Ochratoxigenic Aspergillus Section Nigri Isolated from Grapes by ITS-5.8S rDNA Sequencing Analysis and In Silico RFLP. J. Phytopathol. 2013, 161, 280–283. [Google Scholar] [CrossRef]
- Bragulat, M.R.; Abarca, M.L.; Cabañes, F.J. An easy screening method for fungi producing ochratoxin A in pure culture. Int. J. Food Microbiol. 2001, 71, 139–144. [Google Scholar] [CrossRef]
- Nguyen, K.T.N.; Ryu, D. Concentration of ochratoxin A in breakfast cereals and snacks consumed in the United States. Food Control 2014, 40, 140–144. [Google Scholar] [CrossRef]
- Gomez, K.A. Statistical Procedures for Agricultural Research; John Wiley and Sons: New York, NY, USA, 1984. [Google Scholar]

| S. No. | Isolates | * Mean OTA Concentration (µg/kg) |
|---|---|---|
| 1 | AN1 | 2.82 a ± 0.06 |
| 2 | AN2 | 0.18 e ± 0.01 |
| 3 | AN3 | 0.87 cd ± 0.03 |
| 4 | AN4 | 0.62 d ± 0.02 |
| 5 | AN5 | 1.25 b ± 0.01 |
| 6 | AN6 | 1.12 bc ± 0.03 |
| 7 | AN7 | 1.09 bc ± 0.02 |
| 8 | AN8 | 0.70 d ± 0.02 |
| 9 | AN9 | 1.02 bc ± 0.01 |
| 10 | AN10 | 0.25 e ± 0.01 |
| S. No. | Isolates | * Mean OTA Concentration (µg/kg) |
|---|---|---|
| 1 | AO1 | 12.33 i ± 0.07 |
| 2 | AO2 | 31.43 g ± 0.45 |
| 3 | AO3 | 90.75 c ± 0.90 |
| 4 | AO4 | 62.60 d ± 0.11 |
| 5 | AO5 | 19.07 h ± 0.62 |
| 6 | AO6 | 104.74 b ± 0.57 |
| 7 | AO7 | 57.81 d ± 0.57 |
| 8 | AO8 | 38.90 f ± 0.14 |
| 9 | AO9 | 196.84 a ± 0.53 |
| 10 | AO10 | 46.80 e ± 0.13 |
| Calibration Curve | R2 | Linearity Range (µg/kg) | LOD (µg/kg) | LOQ (µg/kg) | Recovery (%) |
|---|---|---|---|---|---|
| y = 217769x + 44486 | 0.998 | 2 to 25 | 0.13 | 0.39 | 80 |
| Analyte | Polished Rice (PR) | Brown Rice (BR) |
|---|---|---|
| * OTA Concentration (µg/kg) | * OTA Concentration (µg/kg) | |
| 1 | 1.24 ± 0.01 | 2.40 ± 0.07 |
| 2 | 1.50 ± 0.03 | 3.35 ± 0.07 |
| 3 | 2.47 ± 0.01 | 11.59 ± 0.06 |
| 4 | ND | 2.06 ± 0.02 |
| 5 | 0.60 ± 0.02 | 3.97 ± 0.05 |
| 6 | 7.61 ± 0.33 | 0.61 ± 0.01 |
| 7 | 1.26 ± 0.05 | 3.37 ± 0.07 |
| 8 | ND | 1.14 ± 0.04 |
| 9 | 3.29 ± 0.09 | 0.98 ± 0.01 |
| 10 | ND | ND |
| 11 | 2.60 ± 0.04 | 2.66 ± 0.03 |
| 12 | 1.24 ± 0.04 | 1.32 ± 0.05 |
| 13 | ND | 2.31 ± 0.01 |
| 14 | 1.91 ± 0.01 | ND |
| 15 | 0.87 ± 0.01 | 2.54 ± 0.06 |
| 16 | ND | 2.76 ± 0.05 |
| 17 | ND | ND |
| 18 | 1.67 ± 0.03 | 3.58 ± 0.02 |
| 19 | 2.91 ± 0.04 | 0.52 ± 0.02 |
| 20 | ND | 2.20 ± 0.03 |
| 21 | 0.75 ± 0.01 | ND |
| 22 | 1.39 ± 0.02 | 3.86 ± 0.04 |
| 23 | 2.82 ± 0.03 | 1.15 ± 0.02 |
| 24 | ND | 2.37 ± 0.04 |
| 25 | 2.50 ± 0.08 | - |
| 26 | 0.56 ± 0.01 | - |
| Analyte | Total No. of Samples | Incidence of OTA n (%) | Frequency of OTA Concentration (µg/kg) No. of Samples | No. of Samples Above EU Limit n (%) | ||||
|---|---|---|---|---|---|---|---|---|
| <1 | 1–<3 | 3–5 | >5 | ND | ||||
| BR | 24 | 20 (83%) | 3 | 11 | 5 | 1 | 4 | 6 (25%) |
| PR | 26 | 18 (69%) | 4 | 12 | 1 | 1 | 8 | 2 (8%) |
Disclaimer/Publisher’s Note: The statements, opinions and data contained in all publications are solely those of the individual author(s) and contributor(s) and not of MDPI and/or the editor(s). MDPI and/or the editor(s) disclaim responsibility for any injury to people or property resulting from any ideas, methods, instructions or products referred to in the content. |
© 2025 by the authors. Licensee MDPI, Basel, Switzerland. This article is an open access article distributed under the terms and conditions of the Creative Commons Attribution (CC BY) license (https://creativecommons.org/licenses/by/4.0/).
Share and Cite
Nandinidevi, S.; Jayapradha, C.; Balachandar, D.; Logrieco, A.F.; Velazhahan, R.; Paranidharan, V. Ochratoxin A and Aspergillus spp. Contamination in Brown and Polished (White) Rice from Indian Markets. Toxins 2025, 17, 474. https://doi.org/10.3390/toxins17100474
Nandinidevi S, Jayapradha C, Balachandar D, Logrieco AF, Velazhahan R, Paranidharan V. Ochratoxin A and Aspergillus spp. Contamination in Brown and Polished (White) Rice from Indian Markets. Toxins. 2025; 17(10):474. https://doi.org/10.3390/toxins17100474
Chicago/Turabian StyleNandinidevi, Sadaiappan, Chandren Jayapradha, Dananjeyan Balachandar, Antonio F. Logrieco, Rethinasamy Velazhahan, and Vaikuntavasan Paranidharan. 2025. "Ochratoxin A and Aspergillus spp. Contamination in Brown and Polished (White) Rice from Indian Markets" Toxins 17, no. 10: 474. https://doi.org/10.3390/toxins17100474
APA StyleNandinidevi, S., Jayapradha, C., Balachandar, D., Logrieco, A. F., Velazhahan, R., & Paranidharan, V. (2025). Ochratoxin A and Aspergillus spp. Contamination in Brown and Polished (White) Rice from Indian Markets. Toxins, 17(10), 474. https://doi.org/10.3390/toxins17100474

